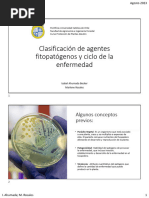

0% encontró este documento útil (0 votos)
33 vistas30 páginasInoculación y Propágulos en Fitopatología
Este documento describe las etapas clave en el desarrollo de las enfermedades de las plantas, incluida la inoculación, la germinación del inóculo y la penetración en los tejidos de la planta. Explica que los patógenos secretan enzimas, toxinas y otros compuestos químicos para debilitar las defensas de la planta y causar síntomas de enfermedad. También señala que la investigación futura debería centrarse en los tipos de enzimas que usan los patógenos y cómo
Cargado por
Juan Pablo CharriaDerechos de autor
© © All Rights Reserved
Nos tomamos en serio los derechos de los contenidos. Si sospechas que se trata de tu contenido, reclámalo aquí.
Formatos disponibles
Descarga como PPTX, PDF, TXT o lee en línea desde Scribd
0% encontró este documento útil (0 votos)
33 vistas30 páginasInoculación y Propágulos en Fitopatología
Este documento describe las etapas clave en el desarrollo de las enfermedades de las plantas, incluida la inoculación, la germinación del inóculo y la penetración en los tejidos de la planta. Explica que los patógenos secretan enzimas, toxinas y otros compuestos químicos para debilitar las defensas de la planta y causar síntomas de enfermedad. También señala que la investigación futura debería centrarse en los tipos de enzimas que usan los patógenos y cómo
Cargado por
Juan Pablo CharriaDerechos de autor
© © All Rights Reserved
Nos tomamos en serio los derechos de los contenidos. Si sospechas que se trata de tu contenido, reclámalo aquí.
Formatos disponibles
Descarga como PPTX, PDF, TXT o lee en línea desde Scribd